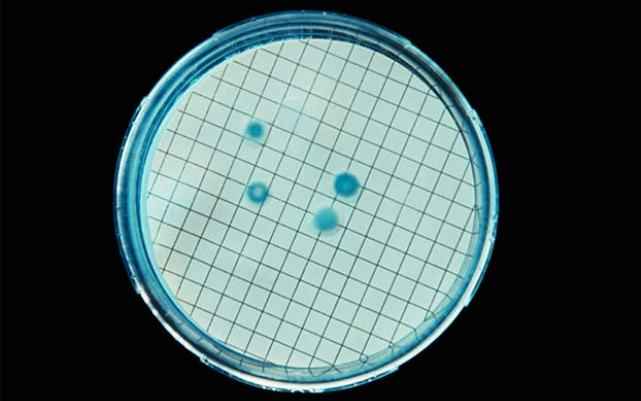
1
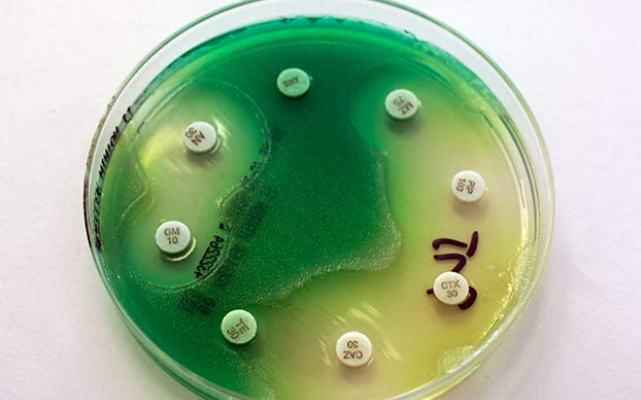
7

Мобильные телефоны уже давно стали настоящим домом для целого ряда микробов, вызывающих как развитие гриппа и конъюнктивита, так и провоцирующих рост смертельно опасных для жизни человека инфекций.
Поэтому в следующий раз, когда надумаете вытащить из кармана свой телефон, чтобы задокументировать ваше очередное “пищевое путешествие”, взгляните на список некоторых бактерий и микроорганизмов, которые оказываются на столе вместе с вашим смартфоном.
10. Колиформ (Coliforms)
В следующий раз, когда вы вдруг почувствуете себя нехорошо, склонившись над едой, задумайтесь, что всему виной может быть ваш мобильный телефон. Микробиологи университета Аризоны пришли к выводу, что смартфоны переносят больше бактерий, чем унитазы.
Эксперты говорят, что ничего удивительного в этом нет: на человеческих бёдрах куда меньше бактерий, чем на ртах и руках, и даже самые рьяные чистюли стирают своё нижнее бельё чаще, чем протирают свой смартфон.
Тем не менее, трудно принять факт, что эти бактерии живут в большом количестве в экскрементах как человека, так и животного, а также поселяются в почве и на растениях.
Ещё одно их любимое место – это мобильный телефон. В то время как небольшое количество этих бактерий на вашем телефоне ещё не повод для беспокойства, однако, их присутствие является показателем того, что на телефоне обитают и другие патогены.
9. Кишечная палочка

Вероятно, вам вряд ли хотелось бы, что эта красота жила на вашем телефоне. Правда заключается в том, что не все штаммы этих бактерий на самом деле вредны. Некоторые из них даже полезны для желудочно-кишечного тракта.
Тип фекальных бактерий кишечной группы, штаммы E.coli, на постоянной основе присутствуют в кишечнике человека, а их наличие на поверхности мобильного свидетельствует о том, что есть и другие вредители.
В редких случаях на телефоне может обитать очень неприятный представитель этой группы: E.coli O157: H7. Этот патоген может привести к появлению тяжёлых судорог, поносу и рвоте. Иногда последствия могут быть фатальными.
8. Золотистый стафилококк

Это ещё один тип бактерий, чья вредоносность зависит от штамма. Некоторые виды могут привести к развитию серьёзных кожных заболеваний. Они называются, как правило, стафилококковые инфекции.
Метициллин-устойчивый золотистый стафилококк, к примеру, – это очень неприятный вид патогена, который заставляет кожу в буквальном смысле кипеть. Он передаётся при контакте с кожей. Это, как правило, распространено в больницах и других медицинских учреждениях, но процесс значительно ускоряется с помощью грязных мобильных телефонов.
В исследовании 2009 года турецкие микробиологи обнаружили, что более половины (52 процента) из 200 проверенных ими телефонов рабочих минздрава оказались заражёнными золотистым стафилококком. Причём 39 процентов инфицированных телефонов были подвержены метициллин-устойчивому типу стафилококка.
7. Стрептококк

Американский ведущий Андерсон Купер (Anderson Cooper) видел многое во время своего пребывания на экране. Седовласый ведущий новостей преследовал смертельно опасного крокодила в подводных пещерах, уклонился от бомбы на Ближнем Востоке, преследовал ураган в Новом Орлеане.
Но главный человек CNN был очень потрясён, когда узнал, что его любимый BlackBerry инфицирован фекальным стрептококком.
Эта бактерия, как правило, “поставляется” в двух формах (группа А и группа В). Первый тип бактерий – это тот, с которым сталкиваются многие из нас, особенно дети, когда болеют ангиной.
Но этот тип может привести к развитию более серьёзных недугов, таких как скарлатина, синдром токсического шока, некротический фасциит. Стрептококк группы В, как правило связан с пневмонией, развитием проблем с мочевыводящими путями, кровью и кожными инфекциями.
6. Коагулазный стафилококк
Этот трудновыговариваемый стафилококк устойчив к антибиотикам, и, как правило, живёт на коже человека или в вагинальном тракте. Хотя в целом он менее вреден, чем золотистый стафилококк, бактерии являются причиной развития инфекций в кровотоке. В том числе это может произойти и в результате контакта с больничными поверхностями или какими-либо предметами медицинского предназначения.
Эти бактерии признаны виновными в развитии около 30 процентов кровяных инфекций у людей, находящихся на стационарном лечении в больницах.
Бактерии также бродят по смартфонам и другим устройствам. В 2011 году группа университетских исследователей из Ганы взяла анализы с поверхности 100 мобильных телефонов, владельцами которых были случайным образом выбранные студенты. В итоге 15 процентов телефонов оказались зараженными этой бактерией.
5. Плесень
Плесень – это не просто то, что вырастает на продукте, которые пролежал в холодильнике месяц, а вы его всё не выкидываете. Плесень оказалась в наличии и на 10 процентах мобильных телефонов работников турецкого министерства здравоохранения.
Безусловно, это выглядит не так “привлекательно” как на стенах в ванной комнате, но также может спровоцировать развитие проблем со здоровьем. Плесень влияет на дыхательную систему, в результате чего налицо одышка, заложенность носа и лихорадка.
4. Дрожжи

Дрожжи, как и некоторые другие в этом списке, служат важной функции, и могут быть как полезными, так и вредными. Безусловно, мир с дрожжами куда более счастливый, с их помощью делают пиццу и пиво. Но вряд ли вам бы хотелось, чтобы ваш мобильный телефон стал домом для этих организмов.
В упомянутом выше исследовании, проводимом турками, дрожжи были найдены на поверхностях 1,5 процентов тестируемых телефонов. Дрожжи – это гриб, который может жить практически в любом месте вашего тела.
Грибковые инфекции вызывают сильнейший зуд. Однако, хорошей новостью является тот факт, что вряд ли вы подхватите его с вашего мобильного устройства, если только вы не проделываете никаких странных вещей со своим телефоном.
3. Клостридии
Клостридии – это бактерии, которые вызывают диарею. Пациенты пожилого возраста или же те, кто в течение длительного времени применяют антибиотики, очень восприимчивы к этой бактерии.
Клостридии также связаны с развитием лихорадки, тошноты, болей в животе и потерей аппетита. Бактерия часто распространяется в больницах. Развитие инфекции у здоровых людей маловероятно, но частое протирание своего мобильного телефона для профилактики всё равно не помешает.
Производители Apple советуют воздержаться от использования каких-либо средств для очистки своих гаджетов, говоря об обычном протирании их мягкой тканью. Другие эксперты используют раствор дистиллированной воды и изопропилового спирта, распылённый на мягкую ткань для протирания.
2. Коринебактерии (Corynebacterium)

Это токсичный возбудитель дифтерии, потенциально смертельного заболевания, при котором токсины окутывают горло инфицированного и не дают ему дышать. Дифтерия начинается ознобом, а заканчивается жаром и сердечным приступом.
К счастью, прививки от этой болезни находятся в широком доступе в развитых и развивающихся странах. В развитых странах процент заболевания дифтерией практически нулевой. Это означает, что найденные Corynebacterium на мобильных телефонах в рамках исследования, вероятно, оказались безвредными.
1. Синегнойная палочка
Этот оппортунистический патоген, как описала бактерию одна команда микробиологов, способна быть активной в самых разных условиях. Ей нужно совсем немного питания, а проживать она может на различных поверхностях, как, к примеру, на раковинах или в общественных бассейнах, так и на безобидных с первого взгляда экранах телефонов.
В исследовании нигерийских ученых было обнаружено, что эта палочка поселилась на 400 телефонах, что делает её самым распространенным жителем наших гаджетах.
Что отличает синегнойную палочку от других бактерий в этом списке, так это её удивительная способность противостоять лечению после заражения. Наиболее серьёзные проблемы, вызванные этими бактериями, развиваются у пациентов больниц, находящихся на интенсивной терапии.
Это довольно веская причина, чтобы регулярно следить за чистотой вашего телефона.
Источник: infoniac.ru
